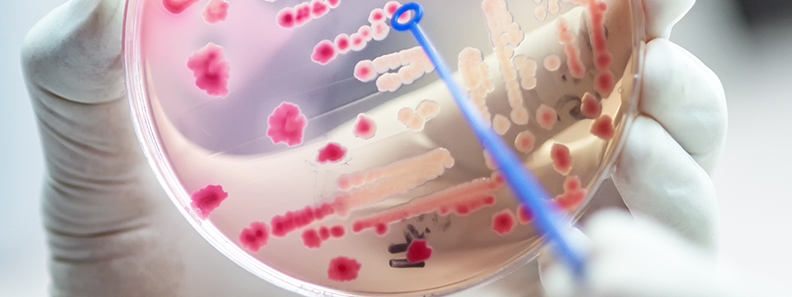
Microbiology

Policy Developments
- Policy Developments
- IFT Comments
- Food Safety Modernization Act (FSMA)
- International Authorities
- Policy News
Policy Developments
- Policy Developments
- IFT Comments
- Food Safety Modernization Act (FSMA)
- International Authorities
- Policy News
IFT Comments
IFT is dedicated to providing scientific perspective on food and nutrition-related issues. Review IFT’s comments for insight into IFT’s input on policy, legislative, regulatory, and other deliberations.
Food Safety Modernization Act (FSMA)
Passed in 2011, FSMA mandates the FDA to require comprehensive, prevention-based controls across the food supply. As such, FSMA enables the FDA to focus on preventing rather than reacting to outbreaks when they occur.
International Resources
The Institute of Food Technologists has compiled resources regarding international developments in food and nutrition. Stay abreast of global conversations in the science of food and nutrition with these scientific, policy, regulatory, and standards-related resources.